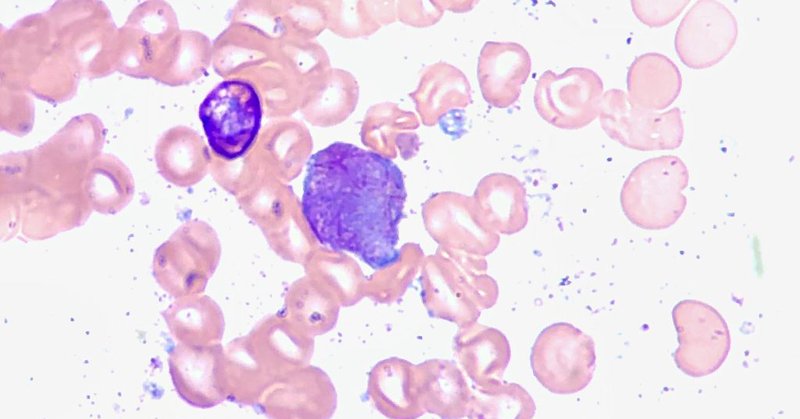
Tweet card summary image

Massachusetts Medical Society (MMS)
@MassMedical
Followers
12K
Following
3K
Media
3K
Statuses
20K
The MMS, with some 25,000 physicians and student members, is dedicated to educating and advocating for the #patients and #physicians of Massachusetts.
Waltham, Massachusetts
Joined April 2009
The Massachusetts Medical Society is the state's largest physician-led organization and a leadership voice in health care policy, public health, and clinical medical education. Learn where you can follow the MMS via social media and our free newsletters: https://t.co/sJ4NHVdmuN
2
0
2
- Follow the MMS on social media: https://t.co/Li4Cgj9cEk - Learn about our advocacy and public health initiatives: https://t.co/tc4mnMtPSI - Learn about membership in the MMS: https://t.co/EhacH36k02 - Discover how our member benefits can help you:
0
0
0
Sign up for our FREE newsletters: - Vital Signs This Week provides advocacy and health care updates: https://t.co/6A55wuMxw0 - Continuing Education Update for upcoming CME programs: https://t.co/WfFpotqtSE - MediaWatch is a roundup of health care news:
1
0
0
“Respiratory viruses, like COVID-19, the flu and RSV, will continue to pose a challenge this holiday season,” said @OjikutuBisola, commissioner of Public Health and executive director of @HealthyBoston.
bostonherald.com
As the Boston-area COVID wastewater data ticks up ahead of Thanksgiving gatherings, residents can get more free at-home test kits while some local health experts are pushing for a return to masks i…
1
0
3
Called the Sturdy Health Cancer & Specialty Care Medical Office Building, the new facility is planned to be three stories tall, spans more than 60,000 square feet and cost $50 million.
bizjournals.com
The new facility will be over 60,000 square feet and cost $50 million.
0
0
1
The White House on Friday said it plans to appoint Dr. Kimryn Rathmell as the next director of @theNCI, the federal government’s principal agency for cancer research.
thehill.com
The White House on Friday said it plans to appoint W. Kimryn Rathmell as the next director of the National Cancer Institute (NCI), the federal government’s principal agency for cancer researc…
0
0
0
Speaker of the House of Delegates Dr. Melody Eckardt kicks off the #MMSInterim2023 HOD Opening Session!
0
0
1
With Americans set to travel for #Thanksgiving, people who’ve been waiting to get a #FluShot should think about acting now, said epidemiologist Alicia Budd, the CDC’s team lead for domestic flu surveillance.
statnews.com
Flu activity in many parts of the U.S. is starting to rise more rapidly, signaling that flu season is on the horizon, the CDC reported Friday.
0
0
1
Most adults in the United States are not worried about getting sick with COVID-19 or spreading it over the holidays, a new survey from @KFF found.
0
0
1
Americans can order more free COVID-19 tests online for home delivery. The U.S. government is offering to send another round of four at-home virus tests ahead of the typical surge in cases during the winter holiday season.
bostonglobe.com
The US government is offering to send another round of four at-home virus tests ahead of the typical surge in cases during the winter holiday season.
1
1
2
Advances in childhood cancer are a success story in modern medicine. But in the past decade, those strides have stalled for Black and Hispanic youth, opening a gap in death rates, according to a new report.
statnews.com
The overall cancer death rate for children and teenagers in the U.S. in 2021 was 2.38 per 10,000 for Black youth, 2.36 for Hispanics, and 1.99 for whites.
0
0
0
This 6-part series aligns with the Massachusetts Board of Registration in Medicine's training requirement for physicians and other health care professionals who serve an adult population. https://t.co/Oqfq7oYu5O
0
0
1
Register now for the 2023 MMS Annual Oration — The Science and Art of Making Medical Decisions, featuring Dr. John B. Wong of @TuftsMedicalCtr and @TuftsMedSchool. https://t.co/FtVKhORIL3
0
0
0
.@AmerMedicalAsson called on insurance companies, employers, and government programs to cover obesity treatments even as many remain reluctant to pay for them, fearing the costs of covering the drugs at a mass scale.
statnews.com
The American Medical Association Monday called on insurance companies, employers, and government programs to cover obesity treatments.
0
0
0
One of the easiest, most effective ways to support #physicians with #MentalHealth issues, including addiction, is utilizing Physician Health Services. Learn more: https://t.co/1qUT4ksqH1
0
0
0
The FDA granted marketing approval to a home test for #chlamydia and #gonorrhea on Wednesday, the first such authorization of a home test to detect the two most common sexually transmitted infections in this country.
statnews.com
The FDA granted marketing approval to a home test for chlamydia and gonorrhea on Wednesday, the first such authorization.
0
0
1
The MMS sounded the alarm on Wednesday about the need for more primary care doctors in the region, @MMS_President said she was “deeply concerned” about the patient situation at Mass General Brigham amid the state’s workforce shortage.
bostonherald.com
Massachusetts General Hospital and Brigham and Women’s Hospital have limited spots for new primary care patients at some practices, as the Massachusetts Medical Society warns that the lack of…
0
0
1
There was a “staggering” annual rise in #measles cases and deaths in 2022, according to a new report from the WHO and CDC.
reuters.com
There was a “staggering” annual rise in measles cases and deaths in 2022, according to a new report from the World Health Organization (WHO) and the U.S. Centers for Disease Control and Prevention...
0
0
1
“This year’s report shows the state of infant and maternal health in the United States remains at crisis-level, with grave disparities that continue to widen the health equity gap,” said @MarchofDimes President and CEO Dr. Elizabeth Cherot.
statnews.com
In the U.S., 14.6% of Black babies were born preterm, compared to 9.4% of white babies and 9% of Asian babies. Preterm birth is responsible for nearly 16% of infant deaths.
0
1
0
“We are, overall, a very healthy state,” said @MassDPH Commissioner @RobbieForChange. “We are a state with a lot of great health care resources. But we are a state that wants to and will hold ourselves accountable to a much higher level."
wbur.org
Gov. Maura Healey ordered the review of maternal health access across the state, as well as medical services in northern Worcester County, following the controversial decision to close a Leominster...
0
0
0